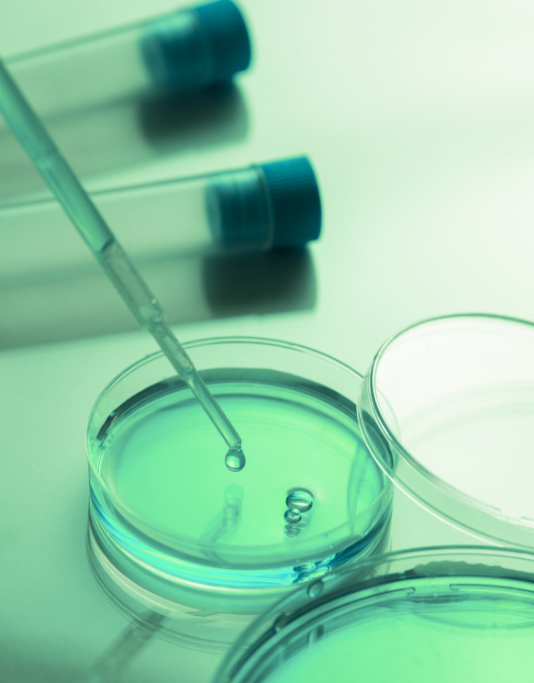

VOC & strategic consulting
for medical product development
and healthtech innovation since 2003
Guiding innovation in medical products and health technology
We support healthcare, MedTech and pharmaceutical organisations in designing, developing and optimising innovative medical products. Our consulting approach combines advanced analytics, healthcare market intelligence and deep sector expertise to guide strategic decision-making across Medical Product Development, Digital Health R&D and MedTech analysis.

MedTech & Devices
We support MedTech organisations in transforming technological innovation into market-ready medical products. Operating at the intersection of healthcare, data and engineering, we help teams navigate complex clinical, regulatory and commercial environments with clarity and precision.
Our work spans the full spectrum of Medical Product Development, from early market opportunity assessment to product definition, pricing and positioning. By integrating HealthTech insights, MedTech analysis and advanced market intelligence, we enable evidence-based decisions that strengthen differentiation, accelerate adoption and reduce development risk.

Pharma & Biotech
We partner with pharmaceutical and biotech organisations to support strategic decision-making across innovation, development and commercialisation pathways. Our expertise combines scientific understanding with structured market insight to inform high-stakes choices in complex and regulated environments.
From Tech Transfer Research and market opportunity assessment to positioning and post-launch studies, we provide decision-ready intelligence that aligns scientific value with market realities. Our approach supports portfolio prioritisation, value articulation and long-term impact across Pharma & Biotech ecosystems.
Trusted by healthcare and MedTech decision-makers
We work with established pharmaceutical companies, global medical device manufacturers and emerging HealthTech innovators. Our clients value our ability to address complex strategic questions with intellectual rigour, sector fluency and discretion.
Our role is not to sell solutions, but to provide clarity where strategic uncertainty is highest.

Engage with our experts
If you are looking to strengthen your Medical Product Development strategy, optimise Digital Health R&D or gain advanced MedTech analysis grounded in robust data, we invite you to engage with our consulting team.

